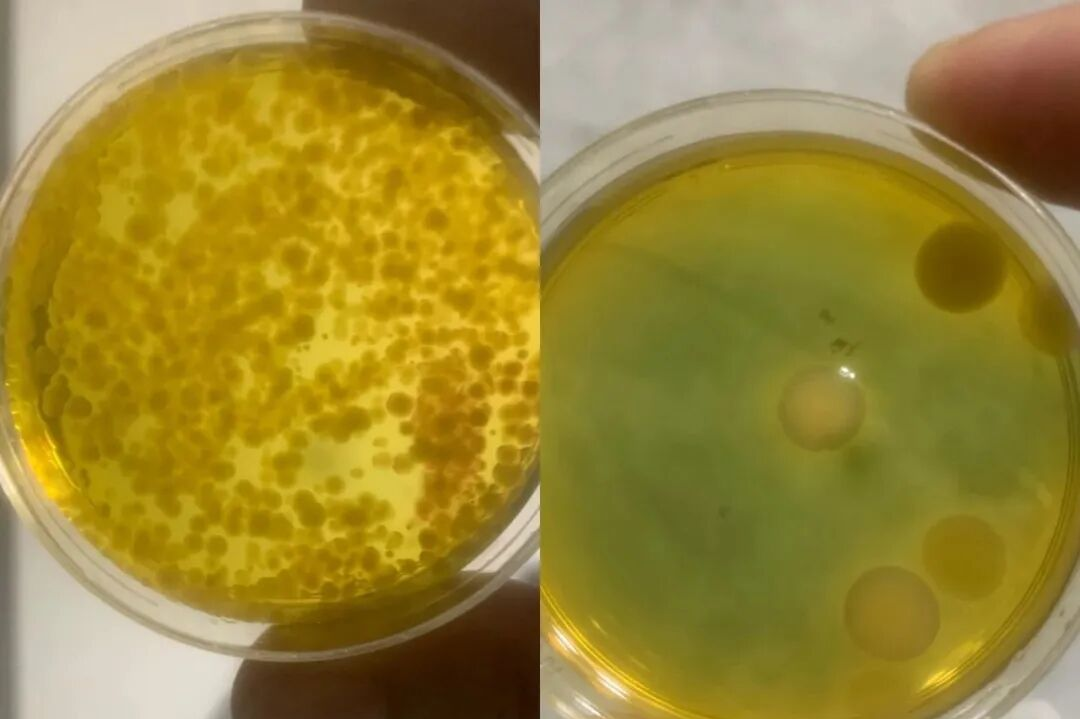

一、弧菌爆发的紧急处置:科学消毒
一旦检测发现弧菌数量异常升高,或肝胰腺/组织内检出大量弧菌)或观察到典型病症(如空肠空胃、肝胰腺萎缩、体表溃疡、游塘、摄食骤减),立即启动消毒程序是阻断传播、降低环境病原负荷的关键第一步。

消毒剂选择与应用要点:含氯消毒剂(漂白粉、次氯酸钠):高效、经济、广谱。关键在于精准计算有效氯浓度(通常水体使用0.2-1.0 ppm有效氯)。务必考虑水体pH值(碱性降低效果)、有机物含量(消耗有效氯)和温度(低温效果差)。消毒后必须彻底中和余氯(硫代硫酸钠),避免对养殖生物造成二次伤害。
过硫酸氢钾复合盐(单过钾):强氧化剂,兼具增氧、改底功效。推荐使用含量≥50%的粉剂或片剂(1公斤/亩·米)。其分解产物无残留毒性,相对安全,但需注意其对部分藻类的杀灭作用。
消毒操作核心原则:
精准计算:依据水体体积、产品有效成分含量精确计算用量,宁少勿滥。
环境评估:密切关注天气(避免雨天、闷热天)、溶氧(消毒前增氧)和养殖动物状态(极度虚弱时慎用)。
效果验证: 这一步非常重要,消毒后24-48小时,务必进行弧菌(TCBS培养基)和总菌落计数,评估消毒效果,消毒效果差请换一种产品,毕竟市面上动保行业太乱。
消毒前后对比
二、 消毒后的关键步骤:解毒与生态修复基础
解毒处理:根据使用的消毒剂类型,针对性解毒(如硫代硫酸钠中和余氯,有机酸/VC缓解应激,沸石粉吸附残留)。
底质改良:弧菌常富集于池底有机质。消毒后及时使用过硫酸氢钾或高铁酸盐类底改产品氧化分解底部有机物(耗氧源),减少弧菌滋生温床。
三、 生物干预的核心:补充有益菌或噬菌体
消毒后水体微生物群落处于“真空期”,此时是引入有益微生物、定向塑造健康微生态的黄金窗口期。目标在于快速建立以有益菌为主导的群落结构,通过竞争性排斥、抗菌物质抑制、免疫增强等机制持续压制弧菌复苏。
应用要点:“复合”优于“单一”:选择科学配比的复合益生菌产品,发挥协同效应(如芽孢杆菌+乳酸菌)。
足量、持续:首次补充需足量(按产品说明高剂量使用),市面上的动保大部分含量都是虚高,后续根据水质和养殖情况定期补充维持。
使用噬菌体“靶向裂解弧菌”,噬菌体作用机理:噬菌体是感染并裂解特定细菌的病毒。其特异性极强,能精准识别并侵入目标弧菌(如副溶血弧菌噬菌体),在其体内复制增殖,最终导致细菌细胞破裂(裂解)死亡,释放出新一代噬菌体继续感染周围同种弧菌。
噬菌体优势有高度特异性:只裂解目标弧菌,不伤害有益菌群、养殖生物和环境,生态友好。在宿主存在时可指数级增长,效果持续,无化学残留问题。对抗耐药菌:是应对抗生素耐药性弧菌的有效替代方案。剂量与时机:首次应用需高剂量“饱和攻击”,确保快速降低病原载量。通常在消毒后、弧菌开始有复苏迹象时(或根据检测)及时投放。细菌抗性:弧菌可能进化出抗性。使用噬菌体(多种噬菌体混合)可有效降低抗性产生风险。
面对养殖弧菌爆发,单一的消毒如同“治标不治本”。科学流程应为:快速精准消毒 > 彻底解毒与基础修复 > 及时足量补充有益菌或/和应用靶向噬菌体 -> 强化综合管理。益生菌通过生态占位和代谢抑制构建长期防御,噬菌体则提供精准高效的“斩首行动”。
文章来源:公众号“水产笔墨者”



 技术推广
技术推广  盐城市农业农村局
盐城市农业农村局